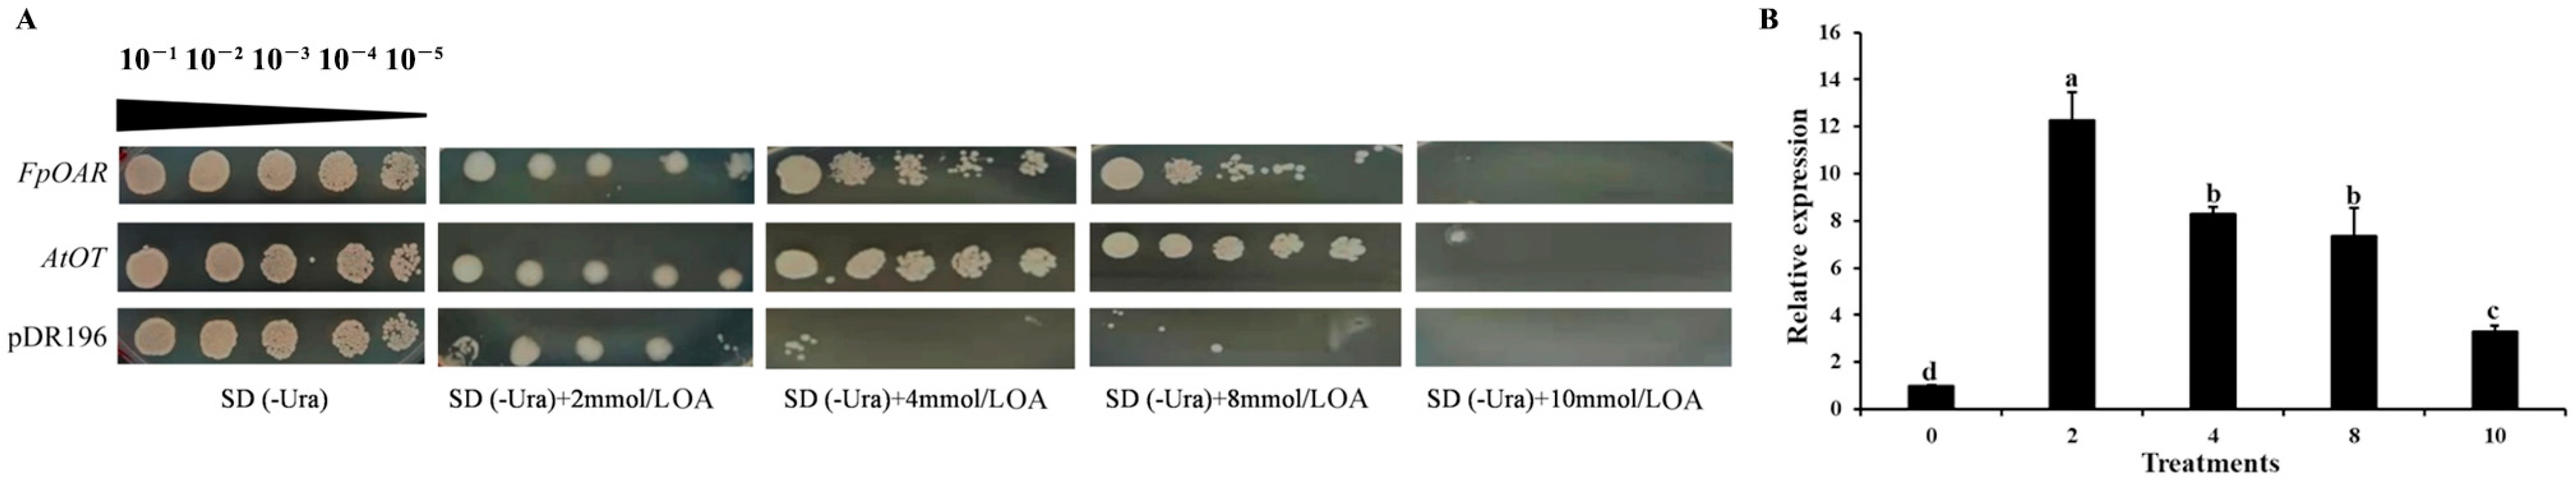
Ijms 24 04516 g005

An Oxalate Transporter Gene, AtOT, Enhances Aluminum Tolerance in Arabidopsis thaliana by Regulating Oxalate Efflux
Abstract
1. Introduction
2. Results
2.1. AtOT Cloning and Sequence Analysis
2.2. Expression Patterns of AtOT
2.3. Subcellular IzationLocalization of AtOT
2.4. Reverse Genetic Analysis of AtOT in Arabidopsis
2.5. Functional Characterization of AtOT in Yeast
3. Discussion
4. Materials and Methods
4.1. Materials and Treatments
4.2. RNA Extraction, cDNA Synthesis, and qRT-PCR Analysis
4.3. Cloning and Bioinformatics Analysis
4.4. Subcellular Localization of AtOT in N. benthamiana
4.5. Homozygous Identification and Reverse Genetic Analysis of AtOT in Arabidopsis
4.6. Oxalic Acid Resistance and Aluminum Tolerance of AtOT in Yeast
4.7. Statistical Methods
5. Conclusions
Supplementary Materials
Author Contributions
Funding
Institutional Review Board Statement
Informed Consent Statement
Data Availability Statement
Acknowledgments
Conflicts of Interest
References
- Kochian, L.V.; Hoekenga, O.A.; Piñros, M.A. How do crop plants tolerate acid soils? Mechanisms of aluminum tolerance and phosphorous efficiency. Annu. Rev. Plant Biol. 2004, 55, 459–493. [Google Scholar] [CrossRef] [PubMed]
- Silambarasan, S.; Logeswari, P.; Valentine, A.; Cornejo, P. Role of Curtobacterium herbarum strain CAH5 on aluminum bioaccumulation and enhancement of Lactuca sativa growth under aluminum and drought stresses. Ecotoxicol. Environ. Saf. 2019, 183, 109573.1–109573.10. [Google Scholar] [CrossRef] [PubMed]
- Feng, Y.M.; Yu, M.; Wang, C.Q.; Liu, J.Y. Aluminum toxicity induced cell responses in higher plants. J. Huazhong Agric. Univ. 2005, 24, 320–324. [Google Scholar]
- Zhang, H.; Zhang, G.L.; Zhao, Y.G.; Zhao, W.J.; Qi, Z.P. Chemical degradation of a Ferralsol (Oxisol) under intensive rubber (Hevea Brasiliensis) farming in tropical China. Soil Tillage Res. 2007, 93, 109–116. [Google Scholar] [CrossRef]
- Wang, H.; Chen, R.F.; Iwashita, T.; Ma, J.F. Physiological characterization of aluminum tolerance and accumulation in tartary and wild buckwheat. New Phytol. 2015, 205, 273–279. [Google Scholar] [CrossRef]
- Poschenrieder, C.; Gunsé, B.; Corrales, I.; Barceló, J. A glance into aluminum toxicity and resistance. Sci. Total Environ. 2008, 400, 356–368. [Google Scholar] [CrossRef]
- Rahman, R.; Upadhyaya, H. Aluminum toxicity and its tolerance in plant: A Review. J. Plant Biol. 2021, 64, 101–121. [Google Scholar] [CrossRef]
- Ma, J.F. Syndrome of aluminum toxicity and diversity of aluminum resistance in higher plants. Int. Rev. Cytol. 2007, 264, 225–252. [Google Scholar]
- Wang, H.; Yin, X.; Du, D.; Liang, Z.; Han, Z.; Nian, H.; Ma, Q. GsMYB7 encoding a R2R3-type MYB transcription factor enhances the tolerance to aluminum stress in soybean (Glycine max L.). BMC Genom. 2022, 23, 529. [Google Scholar] [CrossRef]
- Yang, J.L.; He, Y.F.; Zheng, S.J. Research progresses in aluminum tolerance mechanisms in plants. Plant Nutr. Fertil. Sci. 2005, 11, 836–845. [Google Scholar]
- Ryan, P.R.; Tyerman, S.D.; Sasaki, T.; Furuichi, T.; Yamamoto, Y.; Zhang, W.H.; Delhaize, E. The identification of aluminum-resistance genes provides opportunities for enhancing crop production on acid soils. J. Exp. Bot. 2011, 62, 9–20. [Google Scholar] [CrossRef] [PubMed]
- Ma, J.F. Role of organic acids in detoxification of aluminum in higher plants. Plant Cell Physiol. 2000, 41, 383–390. [Google Scholar] [CrossRef] [PubMed]
- You, J.F.; Yang, Z.M. Organic acid secretion and its detoxification mechanism in plant roots under aluminum stress. J. Plant Physiol. Mol. Biol. 2005, 31, 111–118. [Google Scholar]
- Ma, J.F. High aluminum resistance in buckwheat. II. Oxalic acid detoxifies aluminum internally. Plant Physiol. 1998, 117, 753–759. [Google Scholar] [CrossRef]
- Zheng, J.S.; Ma, J.F. High aluminum resistance in buckwheat. I. Al-induced specific secretion of oxalic acid from root tips. Plant Physiol. 1998, 117, 745–751. [Google Scholar] [CrossRef]
- Delhaize, E.; Gruber, B.D.; Ryan, P.R. The roles of organic anion permeases in aluminum resistance and mineral nutrition. FEBS Lett. 2007, 581, 2255–2262. [Google Scholar] [CrossRef]
- Yang, J.L.; Fan, W.; Zheng, S.J. Mechanisms and regulation of aluminum-induced secretion of organic acid anions from plant roots. J. Zhejiang Univ. Sci. 2019, 20, 513–527. [Google Scholar] [CrossRef]
- Zhang, X.; Long, Y.; Huang, J.; Xia, J. Molecular mechanisms for coping with Al toxicity in plants. Int. J. Mol. Sci. 2019, 20, 1551. [Google Scholar] [CrossRef]
- Jiang, Q.; Gao, Z.X.; Lv, Z.Y.; Hu, H.J.; Han, C. Research progress on the mechanism of plant resistance to aluminum toxicity. S. China Agric. 2016, 10, 211–213. [Google Scholar]
- Ma, J.F.; Ryan, P.R.; Delhaize, E. Aluminum tolerance in plants and the complexing role of organic acids. Trends Plant Sci. 2001, 6, 273–278. [Google Scholar] [CrossRef]
- Liu, J.P.; Magalhaes, J.V.; Shaff, J.; Kochian, L.V. Aluminum-activated citrate and malate transporters from the MATE and ALMT families function independently to confer Arabidopsis aluminum tolerance. Plant J. 2009, 57, 389–399. [Google Scholar] [CrossRef] [PubMed]
- Hoekenga, O.A.; Maron, L.G.; Piñeros, M.A.; Cançado, G.M.A.; Shaff, J.; Kobayashi, Y.; Ryan, P.R.; Dong, B.; Delhaize, E.; Sasaki, T.; et al. From the cover: AtALMT1, which encodes a malate transporter, is identified as one of several genes critical for aluminum tolerance in arabidopsis. Proc. Natl. Acad. Sci. USA 2006, 103, 9738–9743. [Google Scholar] [CrossRef] [PubMed]
- Yokosho, K.; Yamaji, N.; Fujii-Kashino, M.; Ma, J.F. Functional analysis of a MATE gene OsFRDL2 revealed its involvement in Al-induced secretion of citrate, but a lower contribution to Al tolerance in rice. Plant Cell Physiol. 2016, 57, 976–985. [Google Scholar] [CrossRef] [PubMed]
- Yokosho, K.; Yamaji, N.; Ma, J.F. An Al-inducible MATE gene is involved in external detoxification of Al in rice. Plant J. 2011, 68, 1061–1069. [Google Scholar] [CrossRef] [PubMed]
- Ligaba, A.; Katsuhara, M.; Ryan, P.R.; Shibasaka, M.; Matsumoto, H. The BnALMT1 and BnALMT2 genes from rape encode aluminum-activated malate transporters that enhance the aluminum resistance of plant cells. Plant Physiol. 2006, 142, 1294–1303. [Google Scholar] [CrossRef]
- Collins, N.C.; Shirley, N.J.; Saeed, M.; Pallotta, M.; Gustafson, J.P. An ALMT1 gene cluster controlling aluminum tolerance at the Alt4 locus of Rye (Secale cereale L.). Genetics 2008, 179, 669–682. [Google Scholar] [CrossRef]
- Liang, C.; Piñeros, M.A.; Tian, J.; Yao, Z.; Sun, L.; Liu, J.; Shaff, J.; Coluccio, A.; Kochian, L.V.; Liao, H. Low pH, aluminum, and phosphorus coordinately regulate malate exudation through GmALMT1 to improve soybean adaptation to acid soils. Plant Physiol. 2013, 161, 1347–1361. [Google Scholar] [CrossRef]
- Melo, J.O.; Martins, L.G.C.; Barros, B.A.; Pimenta, M.R.; Lana, U.G.P.; Duarte, C.E.M.; Pastina, M.M.; Guimaraes, C.T.; Schaffert, R.E.; Kochian, L.V.; et al. Repeat variants for the SbMATE transporter protect sorghum roots from aluminum toxicity by transcriptional interplay in cis and trans. Proc. Natl. Acad. Sci. USA 2019, 116, 313–318. [Google Scholar] [CrossRef]
- Ligaba, A.; Dreyer, I.; Margaryan, A.; Schneider, D.J.; Kochian, L.; Piñeros, M. Functional, structural and phylogenetic analysis of domains underlying the Al sensitivity of the aluminum-activated malate/anion transporter, TaALMT1. Plant J. 2013, 76, 766–780. [Google Scholar] [CrossRef]
- Lv, A.; Wen, W.; Fan, N.; Su, L.; Zhou, P.; An, Y. Dehydrin MsDHN1 improves aluminum tolerance of alfalfa (Medicago sativa L.) by affecting oxalate exudation from root tips. Plant J. 2021, 108, 441–458. [Google Scholar] [CrossRef]
- Qin, C.; Zhang, Y. Research progress of model plant Arabidopsis thaliana. Teach. Middle Sch. Biol. 2009, 9, 6–8. [Google Scholar]
- Li, H.; Wang, N.; Hu, W.; Yan, W.; Jin, X.; Yu, Y.; Du, C.; Liu, C.; He, W.; Zhang, S. ZmNRAMP4 Enhances the Tolerance to Aluminum Stress in Arabidopsis thaliana. Int. J. Mol. Sci. 2022, 23, 8162. [Google Scholar] [CrossRef] [PubMed]
- Du, H.-M.; Liu, C.; Jin, X.-W.; Du, C.-F.; Yu, Y.; Luo, S.; He, W.-Z.; Zhang, S.-Z. Overexpression of the Aldehyde Dehydrogenase Gene ZmALDH Confers Aluminum Tolerance in Arabidopsis thaliana. Int. J. Mol. Sci. 2022, 23, 477. [Google Scholar] [CrossRef] [PubMed]
- Liu, Y.; Xu, J.; Guo, S.; Yuan, X.; Zhao, S.; Tian, H.; Dai, S.; Kong, X.; Ding, Z. AtHB7/12 Regulate Root Growth in Response to Aluminum Stress. Int. J. Mol. Sci. 2020, 21, 4080. [Google Scholar] [CrossRef] [PubMed]
- Liu, Y.-T.; Shi, Q.-H.; Cao, H.-J.; Ma, Q.-B.; Nian, H.; Zhang, X.-X. Heterologous Expression of a Glycine soja C2H2 Zinc Finger Gene Improves Aluminum Tolerance in Arabidopsis. Int. J. Mol. Sci. 2020, 21, 2754. [Google Scholar] [CrossRef]
- Iuchi, S.; Koyama, H.; Iuchi, A.; Kobayashi, Y.; Kitabayashi, S.; Kobayashi, Y.; Ikka, T.; Hirayama, T.; Shinozaki, K.; Kobayashi, M. Zinc finger protein STOP1 is critical for proton tolerance in Arabidopsis and coregulates a key gene in aluminum tolerance. Proc. Natl. Acad. Sci. USA 2007, 104, 9900–9905. [Google Scholar] [CrossRef]
- Han, Z.; Wang, J.; Wang, X.; Zhang, X.; Cheng, Y.; Cai, Z.; Nian, H.; Ma, Q. GmWRKY21, a soybean WRKY transcription factor gene, enhances the tolerance to aluminum stress in Arabidopsis thaliana. Front. Plant Sci. 2022, 13, 833326. [Google Scholar] [CrossRef]
- Badia, M.B.; Maurino, V.G.; Pavlovic, T.; Arias, C.L.; Pagani, M.A.; Andreo, C.S.; Saigo, M.; Drincovich, M.F.; Wheeler, M.C.G. Loss of function of Arabidopsis NADP-malic enzyme 1 results in enhanced tolerance to aluminum stress. Plant J. 2020, 101, 653–665. [Google Scholar] [CrossRef]
- Wei, F.; Hu, J.; Yang, Y.; Hao, Z.-D.; Wu, R.-H.; Tian, B.-M.; Cao, G.-Q.; Zang, X. Transgenic Arabidopsis thaliana expressing a wheat oxalate oxidase exhibits hydrogen peroxide related defense response. J. Integr. Agric. 2015, 14, 2565–2573. [Google Scholar] [CrossRef]
- Chen, X.; Chen, F.; Chen, L.; Zheng, L.; Lu, G.; Wang, Z. Isolation and analysis of oxalic acid insensitive mutant of Arabidopsis thaliana. Chin. J. Biotechnol. 2008, 24, 203–208. [Google Scholar] [CrossRef]
- Watanabe, T.; Shitan, N.; Suzuki, S.; Umezawa, T.; Shimada, M.; Yazaki, K.; Hattori, T. Oxalate efflux transporter from the brown rot fungus Fomitopsis palustris. Appl. Environ. Microbiol. 2010, 76, 7683–7690. [Google Scholar] [CrossRef] [PubMed]
- Yang, Z.; Zhao, P.; Peng, W.; Liu, Z.; Xie, G.; Ma, X.; An, Z.; An, F. Cloning, expression analysis and functional characterization of candidate oxalate transporter genes of HbOT1 and HbOT2 from rubber tree (Hevea brasiliensis). Cells 2022, 11, 3793. [Google Scholar] [CrossRef]
- Luo, C.X.; Shi, Y.M.; Xiang, Y. SNAREs regulate vesicle trafficking during root growth and development. Front. Plant Sci. 2022, 13, 853251. [Google Scholar] [CrossRef] [PubMed]
- Ma, H.N.; Tan, L.Y. Research progress of plant Qa-SNARE protein. Plant Physiol. J. 2014, 50, 132–142. [Google Scholar]
- Jin, H.M.; Li, L.X. Role of Arabidopsis SNARE proteins in vesicle trafficking. Bull. Bot. 2010, 45, 479–491. [Google Scholar]
- Wekesa, C.; Muoma, J.; Reichelt, M.; Asudi, G.; Furch, A.C.U.; Oelmüller, R. The cell membrane of a novel Rhizobium phaseoli strain is the crucial target for aluminum toxicity and tolerance. Cells 2022, 11, 873. [Google Scholar] [CrossRef]
- O’Malley, R.C.; Barragan, C.C.; Ecker, J.R. A user’s guide to the Arabidopsis T-DNA insertion mutant collections. Methods Mol. Biol. 2015, 1284, 323–342. [Google Scholar]
- Reng, X.M.; Wang, W.T.; Tian, H.Y.; Zhou, C.J.; Zhang, H.H. Determination of malondialedhyde content in duck oil by colorimetry. Shandong Agric. Sci. 2014, 46, 117–119. [Google Scholar]
- Decottignies, A.; Grant, A.M.; Nichols, J.W.; de Wet, H.; McIntosh, D.B.; Goffeau, A. ATPase and multidrug transport activities of the overexpressed yeast ABC protein Yor1p. J. Biol. Chem. 1998, 273, 12612–12622. [Google Scholar] [CrossRef]

| Yeast Cells | Culture Time (Day) | |||||||
|---|---|---|---|---|---|---|---|---|
| 0 | 1 | 3 | 5 | 7 | 9 | 11 | 13 | |
| pDR196 | 5 | 4.59 ± 0.082 Aa | 3.87 ± 0.095 Ba | 3.44 ± 0.125 Ba | 3.1 ± 0.066 Ca | 2.89 ± 0.118 Da | 2.78 ± 0.046 Da | 2.76 ± 0.072 Da |
| FpOAR | 5 | 4.09 ± 0.075 Ab | 3.19 ± 0.075 Bab | 2.76 ± 0.095 Cb | 2.64 ± 0.03 Db | 2.55 ± 0.053 DEb | 2.5 ± 0.066 EFb | 2.42 ± 0.05 Fb |
| AtOT | 5 | 4.15 ± 0.089 Ab | 3.16 ± 0.066 Bb | 2.7 ± 0.066 Cb | 2.55 ± 0.108 CDb | 2.46 ± 0.044 Db | 2.43 ± 0.066 Db | 2.38 ± 0.053 Db |
| Yeast Cells | Culture Time (Day) | ||||||
|---|---|---|---|---|---|---|---|
| 1 | 3 | 5 | 7 | 9 | 11 | 13 | |
| pDR196 | 0.025 ± 0.01 Ac | 0.05 ± 0.01 Ab | 0.125 ± 0.018 Bc | 0.175 ± 0.015 Cb | 0.175 ± 0.02 Cc | 0.2 ± 0.023 Cb | 0.2 ± 0.015 Cc |
| FpOAR | 0.05 ± 0.015 Ab | 0.125 ± 0.02 Ba | 0.175 ± 0.015 Cb | 0.225 ± 0.018 Da | 0.225 ± 0.018 Db | 0.225 ± 0.018 Db | 0.25 ± 0.01 Db |
| AtOT | 0.125 ± 0.023 Aa | 0.15 ± 0.026 Aa | 0.225 ± 0.017 Ba | 0.25 ± 0.018 BCa | 0.275 ± 0.025 CDa | 0.3 ± 0.026 Da | 0.35 ± 0.027 Ea |
Disclaimer/Publisher’s Note: The statements, opinions and data contained in all publications are solely those of the individual author(s) and contributor(s) and not of MDPI and/or the editor(s). MDPI and/or the editor(s) disclaim responsibility for any injury to people or property resulting from any ideas, methods, instructions or products referred to in the content. |
© 2023 by the authors. Licensee MDPI, Basel, Switzerland. This article is an open access article distributed under the terms and conditions of the Creative Commons Attribution (CC BY) license (https://creativecommons.org/licenses/by/4.0/).
Share and Cite
Yang, Z.; Zhao, P.; Luo, X.; Peng, W.; Liu, Z.; Xie, G.; Wang, M.; An, F. An Oxalate Transporter Gene, AtOT, Enhances Aluminum Tolerance in Arabidopsis thaliana by Regulating Oxalate Efflux. Int. J. Mol. Sci. 2023, 24, 4516. https://doi.org/10.3390/ijms24054516
Yang Z, Zhao P, Luo X, Peng W, Liu Z, Xie G, Wang M, An F. An Oxalate Transporter Gene, AtOT, Enhances Aluminum Tolerance in Arabidopsis thaliana by Regulating Oxalate Efflux. International Journal of Molecular Sciences. 2023; 24(5):4516. https://doi.org/10.3390/ijms24054516
Chicago/Turabian StyleYang, Zongming, Pingjuan Zhao, Xuehua Luo, Wentao Peng, Zifan Liu, Guishui Xie, Mengyue Wang, and Feng An. 2023. "An Oxalate Transporter Gene, AtOT, Enhances Aluminum Tolerance in Arabidopsis thaliana by Regulating Oxalate Efflux" International Journal of Molecular Sciences 24, no. 5: 4516. https://doi.org/10.3390/ijms24054516
APA StyleYang, Z., Zhao, P., Luo, X., Peng, W., Liu, Z., Xie, G., Wang, M., & An, F. (2023). An Oxalate Transporter Gene, AtOT, Enhances Aluminum Tolerance in Arabidopsis thaliana by Regulating Oxalate Efflux. International Journal of Molecular Sciences, 24(5), 4516. https://doi.org/10.3390/ijms24054516

